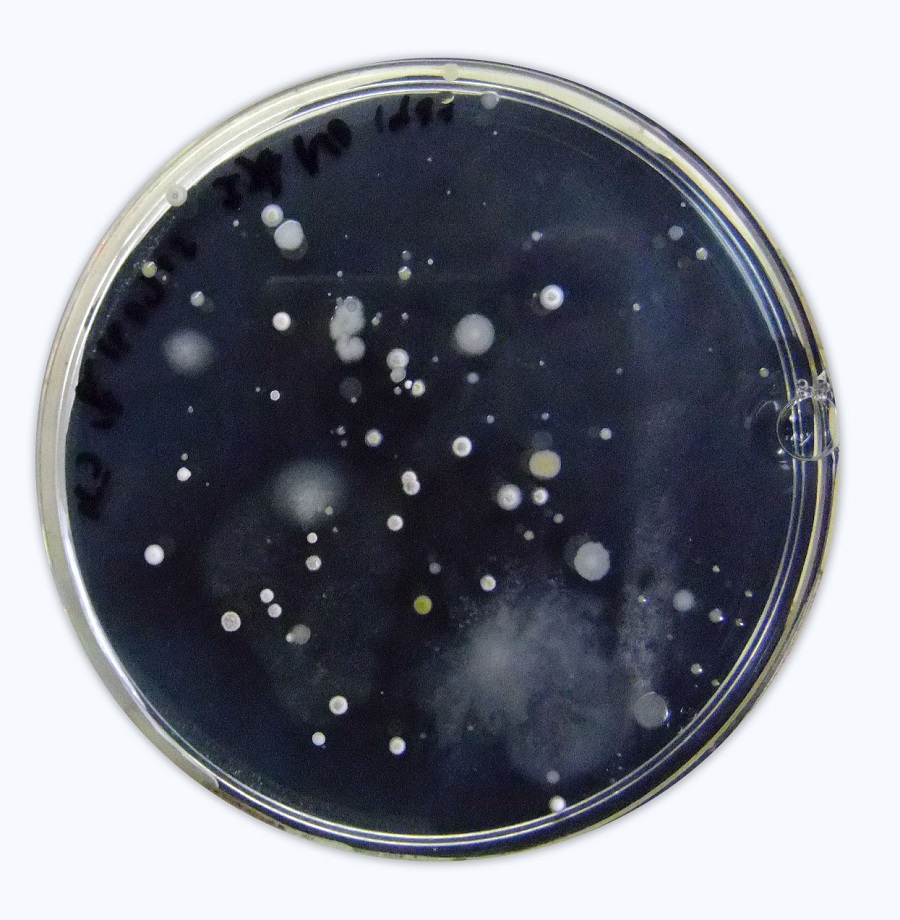
コロニー

事業者へのインタビュー:株式会社林原
 事業者へのインタビュー
事業者へのインタビュー


(左)販売促進課長 岡部由美子さん
株式会社林原は、1883年に水飴製造からスタートし、自然の恵みである微生物や酵素の力を自然由来の素材と掛け合わせるモノづくりの技術で、製菓、健康食品、パーソナルケア、医薬品など多様な領域に素材を提供する研究開発型企業です。
この度、企業のSDGsの取組について、経営デザイン部長 竹本圭佑さん、フードシステムソリューションズ部門 事業戦略部 販売促進課長 岡部由美子さんにお話を伺いましたのでその内容を紹介いたします。
自然の力を活用したモノづくり
当社は、今から139年前に、米のでんぷんから水飴を作ったことから始まり、土中から微生物が作った有用な酵素を探し出して、でんぷんに作用させることで、様々な糖質を開発する研究を行ってきました。そうしてできた糖質の性質を探り、新たな用途を見出して、様々な素材を創り出し、製菓、健康食品、パーソナルケア、医薬品など多様な領域に素材を提供しています。
研究に利用する酵素は、土壌の中から新規の独自酵素を探索することが特徴です。遺伝子情報を活用したデータベースからの探索も行っていますが、今でも、色々な場所から土を集めては、微生物を培養して酵素を分離し、その特性を探ることも続けています。バイオテクノロジーというと魔法のように答えが出てくるように思われるかもしれませんが、実際はこうした地道な調査をこつこつと続けることで新たな素材を創り出しています。
 研究の流れ
研究の流れ コロニー
コロニーありたい姿を実現するために ~サステナビリティコミュニケーション
 当社では、2022年4月に「サステナビリティコミュニケーションブック」を発行しました。サステナビリティを経営に取り込むことで社会と会社双方のためになるようにという想いで作成しており、社外のステークホルダーの皆様とはもちろん、社員間でのコミュニケーションを深めるために活用しています。
当社では、2022年4月に「サステナビリティコミュニケーションブック」を発行しました。サステナビリティを経営に取り込むことで社会と会社双方のためになるようにという想いで作成しており、社外のステークホルダーの皆様とはもちろん、社員間でのコミュニケーションを深めるために活用しています。
創業当時から自然の恵みとともに歩んできた当社の哲学は、SDGsやサステナビリティとマッチしています。当社のマテリアリティは、部門横断の若手や中堅メンバーで作成しましたが、上層部の考える経営の方向性と一致していました。
その後、当社だからこそ取り組むべき社会課題を、4つのマテリアリティを軸とした「サステナビリティ方針」にまとめ、コミュニケーションブックでは、そのエッセンスを紹介しています。
SDGsの掲げるサステナビリティ課題は複雑で難しく、その解決のためにはステークホルダーとの信頼関係の強化と価値共創が欠かせません。このコミュニケーションブックをきっかけに、当社の想いや活動を、国内外はもちろん、社内にも伝えて、同じ志を持つ多くの人と出会い、連携することを願っています。
「林原ビジョン」を実現する指針として、「2030年のありたい姿」を策定
 当社は、自然の恵みである微生物・酵素の力を活用することで独自の素材を開発し、人々の豊かな暮らしを実現するための製品を提供してまいりました。そしてこれからも、技術を研ぎ澄まし、独創的な新素材開発に挑戦し続けてまいります。
当社は、自然の恵みである微生物・酵素の力を活用することで独自の素材を開発し、人々の豊かな暮らしを実現するための製品を提供してまいりました。そしてこれからも、技術を研ぎ澄まし、独創的な新素材開発に挑戦し続けてまいります。
この「林原ビジョン」を実現する指針として、昨今の社会環境の変化を踏まえた「2030年のありたい姿」を策定しました。ありたい姿には、時代とともに変化する社会課題へのソリューションを提供することで、持続可能な社会の実現に貢献し、社会から求められる企業であり続けたいという思いを込めています。
林原のマテリアリティ ~わたしたちの目標~
2019年度に、”2030年に向けて林原は何をすべきか、何ができるのか”をSDGsの観点を含めて議論し、4つのマテリアリティを特定しました。
1.健康寿命延伸への貢献
変化する市場の期待に応えられるように自社の技術を磨きあげ、ユニークで研ぎ澄まされた素材、技術、情報を適切に提供し、世界の人々のウェルネスの実現に貢献します。
2.安定的な食料確保
サプライチェーン全体でのロス削減と、農業・畜産・水産など既存食資源の生産性向上に努めます。また、次世代食資源の開発を産学官のパートナーシップを通じて実施し、持続可能で安定した社会の実現に貢献します。
3.社員エンゲージメントの向上
多種多様な社員が、健康でやりがいを持って働き、個々の能力を最大限に発揮できる職場をつくります。また、社員同士が互いを尊重し、切磋琢磨しながら成長していく環境を提供します。
4.環境負荷の低減
事業活動を通じて自社が発生させる環境負荷を低減する努力を行うとともに、環境課題の解決に貢献する製品や技術開発に前向きに取り組み、地球と共生できる企業を目指します。

生み出された多様な食品素材
1959年に微生物の酵素でぶどう糖の大量製造を果たして以来、自然由来の素材を開発し改革を起こしてきました。それらの中から、特に食品に利用されている素材とそれを活用したSDGsへの貢献をご紹介します。
生み出された多様な食品素材
多機能な糖質「トレハ®(一般名:トレハロース)」
トレハロースは天然に広く分布し、太古の昔から食されてきた糖質の一つです。食品の品質を保つ、水分を保つ、農作物の環境ストレスへの耐性を高めることで生産性を向上させる、といったさまざまな機能を持ち、食品、化粧品、医薬品、アグリ分野など幅広く使われています。
接着力や被膜性に優れる多糖「プルラン」
プルランは糸状菌の一種が水あめを原料にして作り出す水溶性の多糖で、無味無臭の白い粉末です。接着力が強く、食品の結着材として用いられています。被膜性にも優れており、医薬品用のカプセルや錠剤のコーテイングなどにも使用されているユニークな素材です。
水溶性食物繊維「ファイバリクサ®(一般名:イソマルトデキストリン)」
ファイバリクサ®(イソマルトデキストリン)は、粉末状の水溶性食物繊維素材です。色や味、においに与える影響がわずかで、さまざまな食品に無理なく配合でき、手軽に食物繊維を摂ることができます。イソマルトデキストリンは、さまざまな生理機能も研究されています。
水溶性食物繊維「テトラリング®(一般名:環状四糖水飴)」
テトラリング®は液状の水溶性食物繊維素材で、主成分「環状四糖」は日本酒や酒粕のような発酵食品に含まれています。ほのかな甘みとなめらかな粘度が特徴で、低糖質・糖質オフや食物繊維を強化した食品でも、甘味・食感の低下を抑え、健康機能と美味しさの両立を可能とする新世代の食物繊維です。
- ◆アップサイクルによる食品廃棄物削減
 プルラン(接着)、ファイバリクサ®(歯脆さ)、トレハ®(もちもち感)等を活用することで、従来は廃棄していた、まだ食べられる食材を新たな商品に生まれ変わらせるアップサイクルのレシピを開発し、食品素材とともにパートナー企業に提供しています。当社の食品素材を用いてアップサイクルすることで、食品廃棄物削減に貢献することができます。
プルラン(接着)、ファイバリクサ®(歯脆さ)、トレハ®(もちもち感)等を活用することで、従来は廃棄していた、まだ食べられる食材を新たな商品に生まれ変わらせるアップサイクルのレシピを開発し、食品素材とともにパートナー企業に提供しています。当社の食品素材を用いてアップサイクルすることで、食品廃棄物削減に貢献することができます。
- ◆植物を元気にして人と自然に優しい農業を実現
 植物や土壌環境に良好な生理状態をもたらす物質や微生物を含む資材はバイオスティミュラント(BS:Biostimulant、生物刺激剤)と呼ばれ、トレハロースはBSとしても機能することが報告されています。BSは自然由来であり、環境に負荷をかけず、農薬や化学肥料の役割を補ってこれらの過度な使用を抑えることができることから、革新的農業技術として注目されています。
植物や土壌環境に良好な生理状態をもたらす物質や微生物を含む資材はバイオスティミュラント(BS:Biostimulant、生物刺激剤)と呼ばれ、トレハロースはBSとしても機能することが報告されています。BSは自然由来であり、環境に負荷をかけず、農薬や化学肥料の役割を補ってこれらの過度な使用を抑えることができることから、革新的農業技術として注目されています。
- ◆おいしく食べて健康になる食品繊維素材の開発
 食物繊維は消化管機能や腸のぜん動運動の促進、栄養素の吸収を緩慢にするなど、様々な生理作用が知られており「第六の栄養素」と呼ばれることもあります。しかし、日本人の食物繊維摂取は不足しがちであることから、食品に無理なく配合できる食物繊維素材が求められています。
食物繊維は消化管機能や腸のぜん動運動の促進、栄養素の吸収を緩慢にするなど、様々な生理作用が知られており「第六の栄養素」と呼ばれることもあります。しかし、日本人の食物繊維摂取は不足しがちであることから、食品に無理なく配合できる食物繊維素材が求められています。
ファイバリクサ®(イソマルトデキストリン)やテトラリング®(環状四糖水飴)等の水溶性食物繊維素材は、健康機能と美味しさの両立を可能とする新世代の食物繊維です。これらの素材の価値を広くお伝えし、世界中の人においしさと健康を届けられるように、これからも研究を続けていきます。
- ◆L′プラザの紹介
- L′プラザは、1992年に設立したアプリケーション開発のための施設で、藤崎研究所のすぐ近くにあります。調理や食品製造のラボスケール設備、分析設備が整っており、林原製品の用途開発や顧客への提案レシピの作成と試作、顧客の課題解決などを行っています。
試作品を作るチームと分析チームが近くにいるので、何かトラブルが起きた時にはすぐに対応ができ、試作・試食・情報交換ができる開かれた場を提供しています。
その他にも企業向けの社内勉強会や各地の菓子組合向けの講習会なども開催しています。


ステークホルダーとの
信頼関係強化 そして価値共創へ
機能で商品を紹介する営業から、“こんな社会にしていきませんか”“一緒に何か始めませんか”という自分達の価値や未来を考える社会課題を文脈化した営業に変えました。そのおかげでステークホルダーの皆様と、より信頼関係を深める事ができたと考えております。
今後もステークホルダーの皆様のご意見やご要望を企業活動に積極的に取り入れ、共に社会の持続的発展と企業価値の向上に取り組んでまいります。
インタビューのご協力ありがとうございました。
企業が取り組むSDGsの一部です。
お問合せ先
大臣官房 新事業・食品産業部 新事業・国際グループ
代表:03-3502-8111(内線4354)
ダイヤルイン:03-6744-7179






